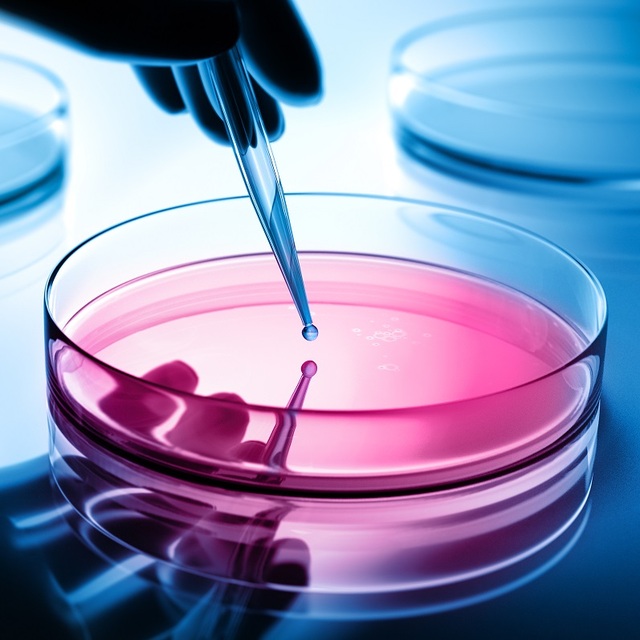

Bellwood: What are some of the main themes or lessons from your career in leading successful transformations?
Kirk: One is the importance of having effective senior sponsorship to support the transformation journey. The sponsorship role is critical, particularly in large organisations with multiple objectives and sometimes competing agendas. In project- or programme-led organisations like BAE Systems, the role of the sponsor is well defined and understood. Increasing levels of understanding of what effective sponsorship looks like should be factored in before launching a transformation programme.
Having a superordinate goal for people to rally around is key. There needs to be a clear driver for change which is recognised and accepted, as opposed to change for change’s sake. Change is easier if it resonates with people, so the goal enables buy-in and can mitigate resistance. It can be the need to meet regulatory requirements, as it was at Network Rail, or to meet contractual commitments. At Rolls-Royce, it was about driving business performance. With the VTF, it’s saving lives.
Rallying people around transformation also requires being sensitive to the culture and aligning messaging accordingly. In Rolls-Royce our programme to drive higher performance was based around ‘developing people to be their best through accessing professional good practice’; in other words, ‘these are the tools to help you do your job well’, rather than driving performance ‘through adherence to centrally defined standards’, where we’re telling you how to do things. Same solution, different message. Transformation must be communicated in ways which appeal to its audience.
It’s also essential to encourage leadership and involvement at all levels. Acceptance and achievement come from the bottom up as well as the top down. One way is to visibly set an example. Walking the talk helps drive a bottom-up ‘embracement’ of change. In Rolls-Royce, we appointed Programme Management Academy ambassadors across the business to help encourage change and professional development. One can’t rely on driving it centrally alone.